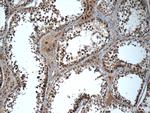
TADA1L Antibody in Immunohistochemistry (Paraffin) (IHC (P))

Search
Proteintech
TADA1L Polyclonal Antibody
{{$productOrderCtrl.translations['antibody.pdp.commerceCard.promotion.promotions']}}
{{$productOrderCtrl.translations['antibody.pdp.commerceCard.promotion.viewpromo']}}
{{$productOrderCtrl.translations['antibody.pdp.commerceCard.promotion.promocode']}}: {{promo.promoCode}} {{promo.promoTitle}} {{promo.promoDescription}}. {{$productOrderCtrl.translations['antibody.pdp.commerceCard.promotion.learnmore']}}
产品信息
20337-1-AP
种属反应
宿主/亚型
分类
类型
抗原
偶联物
形式
浓度
规格
纯化类型
保存液
内含物
保存条件
运输条件
产品详细信息
The MW of this protein is 37 kDa, and 20337-1-AP specifically recognizes the 37 kDa protein.
Immunogen sequence: MATFVSELE AAKKNLSEAL GDNVKQYWAN LKLWFKQKIS KEEFDLEAHR LLTQDNVHSH NDFLLAILTR CQILVSTPDG AGSLPWPGGS AAKPGKPKGK KKLSSVRQKF DHRFQPQNPL SGAQQFVAKD PQDDDDLKLC SHTMMLPTRG QLEGRMIVTA YEHGLDNVTE EAVSAVVYAV ENHLKDILTS VVSRRKAYRL RDGHFKYAFG SNVTPQPYLK NSVVAYNNLI ESPPAFTAPC AGQNPASHPP PDDAEQQAAL LLACSGDTLP ASLPPVNMYD LFEALQVHRE VIPTHTVYAL NIERIITKLW HPNHEELQQD KVHRQRLAAK EGLLLC (1-335 aa encoded by B C015401)
靶标信息
Probably involved in transcriptional regulation.
仅用于科研。不用于诊断过程。未经明确授权不得转售。
篇参考文献 (0)
生物信息学
蛋白别名: HF1L; SPT3-associated factor 42; SPT3-associated factor 42 (STAF42); STAF42; Transcriptional adapter 1; Transcriptional adapter 1-like protein; transcriptional adaptor 1 (HFI1 homolog, yeast); transcriptional adaptor 1 (HFI1 homolog, yeast) like; unnamed protein product
基因别名: 2900026B15Rik; ADA1; D1Ertd251e; hADA1; HFI1; STAF42; TADA1; TADA1L
UniProt ID: (Human) Q96BN2, (Mouse) Q99LM9
Entrez Gene ID: (Human) 117143, (Mouse) 27878